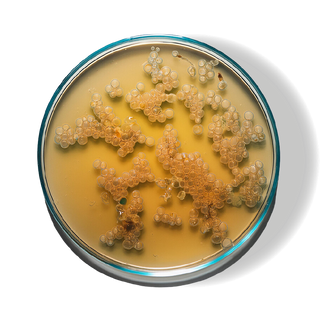

The Ingredients That Make a Difference

We will send you an email to reset your password.
Discover the essence of Korean beauty with Seoul Ceuticals' Polyglutamic Acid Serum. Harnessing the power of nature, this serum is composed of 98% natural ingredients, with 31% being organic. Representing the true spirit of Korean skin care traditions, this product is inspired by age-old secrets that Korean women have trusted for centuries. And true to our ethos, all Seoul Ceuticals products are 100% cruelty-free.
Adding product to your cart
Locks in hydration for radiant skin.
Provides antioxidant protection, while reducing redness and irritation.
Rich in proteins, lipids, and vitamins, royal jelly deeply hydrates the skin, leaving it soft and supple.
Calms redness and hydrates deeply.
Powerhouse hydrator penetrates deeply to plump the skin.
A robust antioxidant that revitalizes and brighens skin.
Soothes, calms, and protects against environmental stressors.
Supports skin elasticity, refines texture, and helps reduce inflammation.
Absolutely. Please read why here: Is Seoul Ceuticals Really Korean?
Yes, we now offer international shipping with a flat shipping fee of $15 for a
maximum of ten items.
If you have any questions, please contact us directly!
Please check your tracking information to ensure your other items aren’t already
on the way! If you have any questions, please reach out to our customer support
directly.
We’re very sorry to hear about that! Please contact us by email at
team@seoulceuticals.com with a photo of the damaged delivery and we’ll be happy to
make things right for you!
Snail mucin is a secretion left by snails as they travel along surfaces, it helps
protect them from environmental irritants and repair injuries. These same properties are what make it effective for human skin, as mucin is packed full of glycolic acid, allantoin, zinc and antiinflammatory vitamins, all of which help
improve overall skin health.
Snail mucin helps moisturize, soothe irritation and boost collagen production in the skin, as well as keep irritants out of your skin in the first place. It is one of the most popular ingredients in Korean beauty regimens and has shown excellent results for millions of users.
Turmeric is a plant in the ginger family that is native to India and Southeast Asia. It is most often seen as a spice in the West, but it is also fantastic for skincare.
Turmeric’s active ingredient curcumin is a potent anti inflammatory ingredient. Turmeric can also brighten the skin and reduce signs of aging by improving your skin’s elasticity.
I use this combination with something else and my skin looks amazing!
مغذي جدا لبشرتي
I love this serum, it hydrated my skin and made it so soft, and the consistency of it feels so rich and soft. I also love how it’s anti aging !
Leaves a beautiful sheen finish to your makeup or works wonderful on a clean face adding firmness & hydration!
I’ve been using this moisturizer for a couple years now, originally ordering through Amazon, but as I try not to support Amazon, I started ordering directly through Seoul Ceuticals and it’s often cheaper and I’m sure of the quality! This is my go-to face cream.